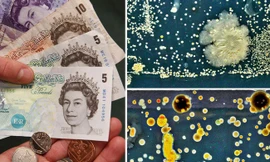
Cực sốc khi biết tiền polymer chúng ta vẫn dùng có thể BẨN đến như thế nào

Giá trị 6 bộ tiền Việt Nam từ năm 1945 đến nay
TPO - Đồng tiền Việt Nam ngoài giá trị tự thân luôn là một vật chứng tin cậy phản ứng trung thực, sinh động tình hình chính trị, quân sự, kinh tế, văn hóa xã hội của đất nước qua các thời kỳ lịch sử. Từ năm 1945 đến nay, tiền giấy Việt Nam trải qua 6 bộ tiền khác nhau.